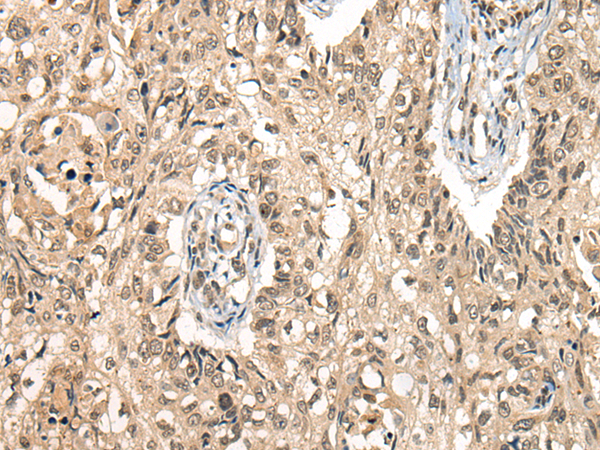

中文名稱:兔抗CDC14B多克隆抗體
英文名稱: Anti-CDC14B rabbit polyclonal antibody
相關(guān)類別: 一抗
抗 原: CDC14B
宿 主: Rabbit
標(biāo) 記 物: Unconjugate
克隆類型: rabbit polyclonal
技術(shù)規(guī)格
|
Background: |
The protein encoded by this gene is a member of the dual specificity protein tyrosine phosphatase family. This protein is highly similar to Saccharomyces cerevisiae Cdc14, a protein tyrosine phosphatase involved in the exit of cell mitosis and initiation of DNA replication, which suggests the role in cell cycle control. This protein has been shown to interact with and dephosphorylates tumor suppressor protein p53, and is thought to regulate the function of p53. Alternative splice of this gene results in 3 transcript variants encoding distinct isoforms. |
|
Applications: |
ELISA, IHC |
|
Name of antibody: |
CDC14B |
|
Immunogen: |
Synthetic peptide of human CDC14B |
|
Full name: |
cell division cycle 14B |
|
Synonyms: |
CDC14B3; Cdc14B1; Cdc14B2; hCDC14B |
|
SwissProt: |
O60729 |
|
ELISA Recommended dilution: |
5000-10000 |
|
IHC positive control: |
Human lung cancer |
|
IHC Recommend dilution: |
25-100 |
購(gòu)物車
購(gòu)物車 幫助
幫助
 021-54845833/15800441009
021-54845833/15800441009
